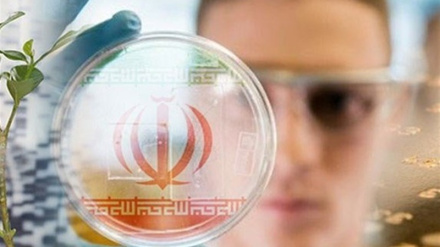
Иран является одним из основных производителей биотехнологических лекарств в Азии

-

Министр здравоохранения Ирана поблагодарил правительство Ирака и медицинских работников за обслуживание во время Арбаина
Сентябрь 08, 2023 10:37Министр здравоохранения, лечения и медицинского образования Ирана, прибывший в Ирак, высоко оценив усилия медицинских работников Ирака и министра здравоохранения этой страны за сотрудничество и предоставление услуг паломникам во время Арбаина Имама Хусейна (мир с ним).
-

Приобретение Ираном новых технологий в области атомной энергетики
Сентябрь 08, 2023 07:56Глава Организации по атомной энергии Ирана заявил: "Несмотря на жестокие санкции, Исламская Республика Иран добилась 158 новых достижений в области атомных энергетических технологий".
-

Эслами: развитие ядерных технологий в различных областях будет продолжено с большей силой
Сентябрь 07, 2023 07:33Вице-президент и глава Организации по атомной энергии Ирана сказал, что ядерные технологии в разных сферах будут развиваться.
-

Захарова назвала позицию ЕС против России неонацистской
Август 31, 2023 10:23В МИД России посчитали неприемлемыми и неонацистскими угрозы главы внешнеполитической службы ЕС Жозепа Борреля лишить российских граждан медицинского обеспечения.
-

Иран - вторая успешная страна в мире по производству рекомбинантной вакцины против гриппа
Август 31, 2023 10:14Мохаммад Амин Гобади, секретарь Тегеранской ассоциации фармацевтов, заявил, что Иран является второй самой успешной страной в мире после США в производстве рекомбинантной вакцины против гриппа, которая достигла этой цели за счет использования современных технологий и сотрудничества элиты биотехнологической индустрии.
-

Исключительное положение иранских ядерных исследовательских лабораторий в регионе Западной Азии
Август 30, 2023 09:52Глава Научно-исследовательского института ядерной науки и технологий Ирана подчеркнул: «Иранские ядерные исследовательские лаборатории являются исключительными в регионе Западной Азии».
-

Иран и Оман развивают оздоровительный туризм
Август 30, 2023 09:39Глава стратегического совета в Центре развития здравоохранения исламских стран сообщил о проведении в Омане международной конференции иранских активистов оздоровительного туризма.
-

Эслами: Ядерные знания были получены, несмотря на 20 лет диверсий
Август 30, 2023 05:59Глава Организации по атомной энергии Ирана заявил: «Ядерные знания Ирана, которые являются движущей силой всех отраслей промышленности, были получены в то время, как за последние 20 лет в этой области произошло множество промышленных диверсий».
-

Минздрав Ирана: ИРИ является одной из успешных моделей здравоохранения в мире
Август 29, 2023 09:00Министр здравоохранения, лечения и медицинского образования Ирана заявил, что Исламская Республика Иран является одной из успешных моделей здравоохранения в мире.
-
Иран является одним из основных производителей биотехнологических лекарств в Азии
Август 28, 2023 06:45Член Ассоциации производителей и экспортеров биотехнологических лекарств, Амин Кобади подчеркнул: "Иран является одним из основных производителей биотехнологических лекарств на Азиатском континенте".